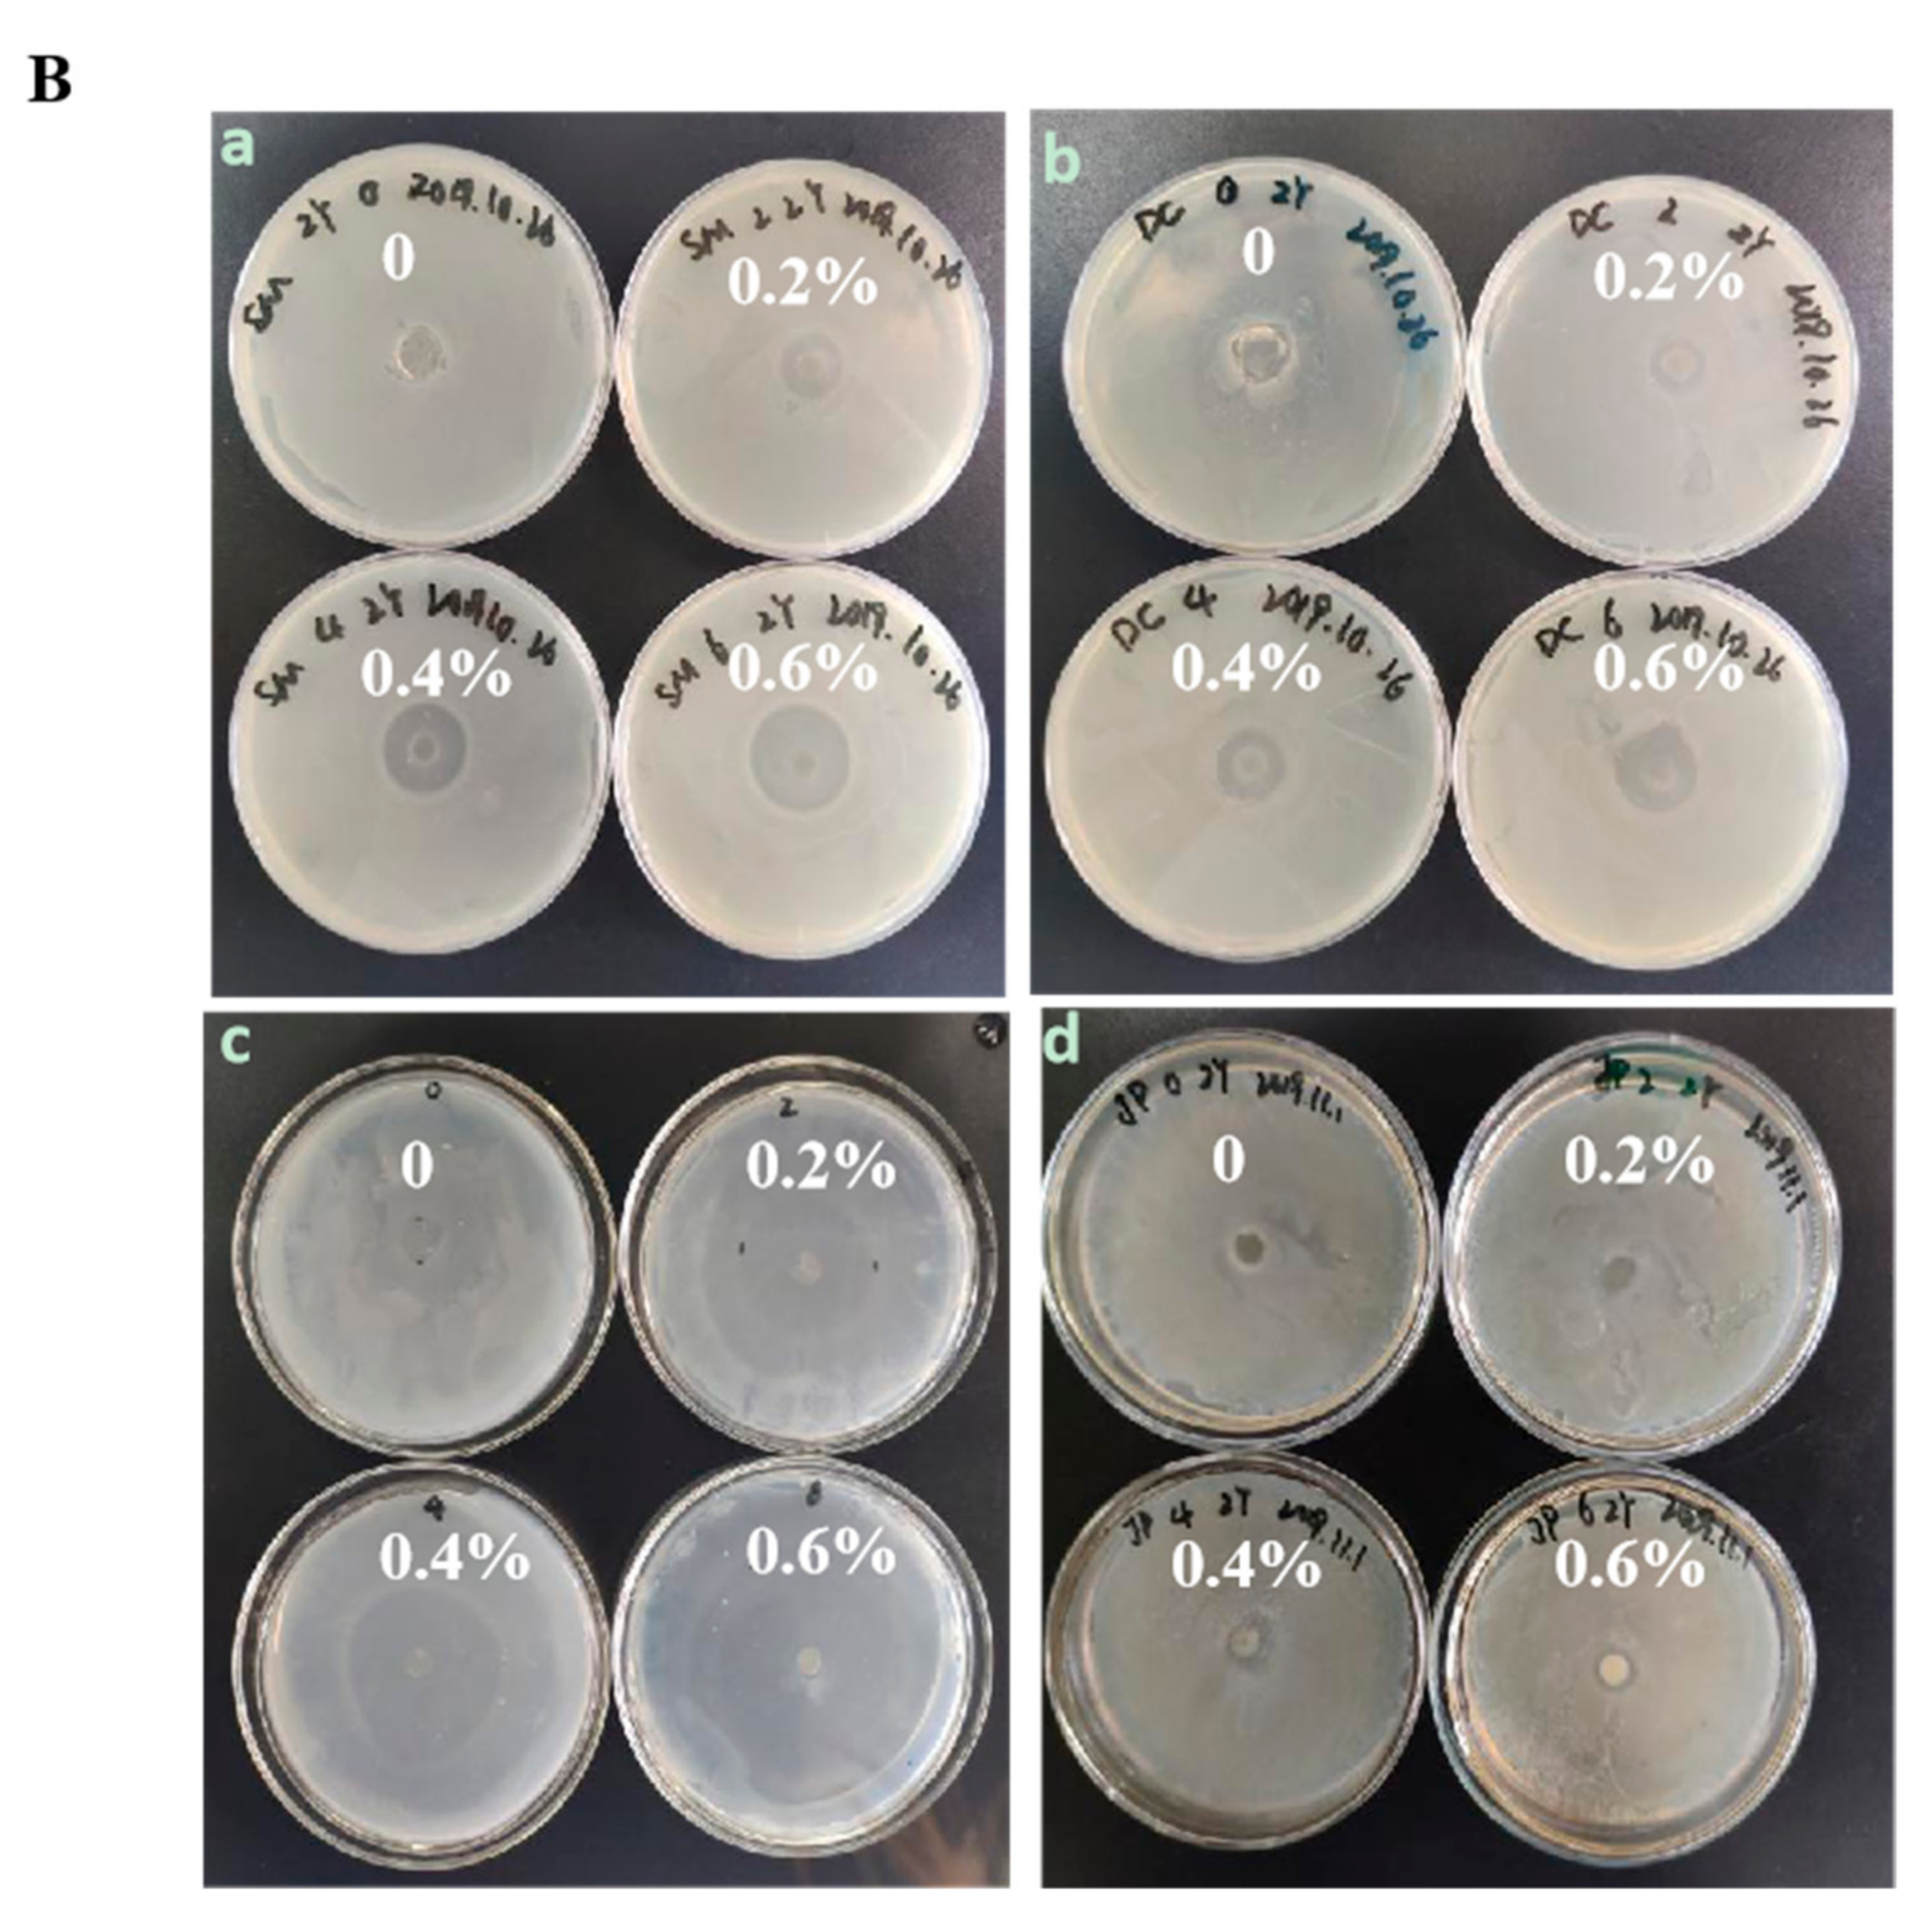
Foods 10 03135 g002b

Preparation and Characterization of Chitosan–Nano-ZnO Composite Films for Preservation of Cherry Tomatoes
Abstract
:1. Introduction
2. Materials and Methods
2.1. Materials
2.2. Preparation of Composite Films
2.3. Properties of Chitosan Containing Different Nano-ZnO
2.3.1. Mechanical Properties
2.3.2. Optical Properties
2.3.3. Water Solubility
2.3.4. Antimicrobial Properties
2.4. Characterization of Composite Film Materials
2.4.1. X-Ray Diffraction (XRD)
2.4.2. Scanning Electron Microscopy (SEM)
2.5. Composite Film Application Study
2.5.1. Evaluation of Quality Parameters
2.5.2. Inoculation Antimicrobial Assay
2.6. Statistical Analyses
3. Results and Discussion
3.1. Choice of Chitosan Film with Optimal Nano-ZnO Concentration
3.1.1. Mechanical Properties
3.1.2. Optical Properties
3.1.3. Water Solubility
3.1.4. Antimicrobial Properties
3.2. Characterization of Composite Film Materials
3.2.1. XRD Analysis
3.2.2. SEM Images
3.3. Cherry Tomato Preservation Using Chitosan Composite Film
3.3.1. SSC Measurements
3.3.2. Color
3.3.3. Respiratory Intensity
3.3.4. Ascorbic Acid Content
3.4. Inoculation Antimicrobial Assay
4. Conclusions
Author Contributions
Funding
Conflicts of Interest
References
- Mangels, A.R.; Holden, J.M.; Beecher, G.R.; Forman, M.R.; Lanza, E. Carotenoid content of fruits and vegetables: An evaluation of analytic data. J. Am. Diet. Assoc. 1993, 93, 284–296. [Google Scholar] [CrossRef]
- Guan, Z.; Biswas, T.; Wu, F. The US Tomato Industry: An Overview of Production and Trade. EDIS 2018, 2, 1027–1030. [Google Scholar]
- De Paiva, E.; Serradilla, M.; Ruiz-Moyano, S.; Córdoba, M.; Villalobos, M.; Casquete, R.; Hernández, A. Combined effect of antagonistic yeast and modified atmosphere to control Penicillium expansum infection in sweet cherries cv. Ambrunés. Int. J. Food Microbiol. 2017, 241, 276–282. [Google Scholar] [CrossRef]
- Laila, A.N.; Joydeep, D.; Sergey, D. Nanocomposite Zinc Oxide-Chitosan Coatings on Polyethylene Films for Extending Storage Life of Okra (Abelmoschus esculentus). Nanomaterials 2018, 8, 479–492. [Google Scholar]
- Moussa, S.H.; Tayel, A.A.; Alsohim, A.S.; Abdallah, R.R. Botryticidal Activity of Nanosized Silver-Chitosan Composite and Its Application for the Control of Gray Mold in Strawberry. J. Food Sci. 2013, 78, M1589–M1594. [Google Scholar] [CrossRef]
- Abdel-Naeem, H.H.; Sallam, K.I.; Malak, N.M. Improvement of the microbial quality, antioxidant activity, phenolic and flavonoid contents, and shelf life of smoked herring (Clupea harengus) during frozen storage by using chitosan edible coating. Food Control 2021, 130, 108317. [Google Scholar] [CrossRef]
- Bi, J.; Tian, C.; Zhang, G.-L.; Hao, H.; Hou, H.-M. Novel procyanidins-loaded chitosan-graft-polyvinyl alcohol film with sustained antibacterial activity for food packaging. Food Chem. 2021, 365, 130534. [Google Scholar] [CrossRef]
- Augusto, A.; Dias, J.R.; Campos, M.J.; Alves, N.M.; Pedrosa, R.; Silva, S.F.J. Influence of Codium tomentosum Extract in the Properties of Alginate and Chitosan Edible Films. Foods 2018, 7, 53. [Google Scholar] [CrossRef] [PubMed] [Green Version]
- Motelica, L.; Ficai, D.; Ficai, A.; Truşcă, R.-D.; Ilie, C.-I.; Oprea, O.-C.; Andronescu, E. Innovative Antimicrobial Chitosan/ZnO/Ag NPs/Citronella Essential Oil Nanocomposite—Potential Coating for Grapes. Foods 2020, 9, 1801. [Google Scholar] [CrossRef] [PubMed]
- Youssef, A.M.; El-Sayed, S.M. Bionanocomposites materials for food packaging applications: Concepts and future outlook. Carbohydr. Polym. 2018, 193, 19–27. [Google Scholar] [CrossRef]
- Espitia, P.J.P.; Soares, N.d.F.F.; Coimbra, J.S.d.R.; de Andrade, N.J.; Cruz, R.S.; Medeiros, E.A.A. Zinc Oxide Nanoparticles: Synthesis, Antimicrobial Activity and Food Packaging Applications. Food Bioprocess Technol. 2012, 5, 1447–1464. [Google Scholar] [CrossRef]
- Siddiqi, K.S.; ur Rahman, A.; Husen, A. Properties of Zinc Oxide Nanoparticles and Their Activity Against Microbes. Nanoscale Res. Lett. 2018, 13, 141–143. [Google Scholar] [CrossRef]
- Jayasuriya, A.C.; Aryaei, A.; Jayatissa, A.H. ZnO nanoparticles induced effects on nanomechanical behavior and cell viability of chitosan films. Mater. Sci. Eng. C 2013, 33, 3688–3696. [Google Scholar] [CrossRef] [PubMed] [Green Version]
- Yamamoto, O. Influence of particle size on the antibacterial activity of zinc oxide. Int. J. Inorg. Mater. 2001, 3, 643–646. [Google Scholar] [CrossRef]
- Rahman, P.M.; Mujeeb, V.A.; Muraleedharan, K. Flexible chitosan-nano ZnO antimicrobial pouches as a new material for extending the shelf life of raw meat. Int. J. Biol. Macromol. 2017, 97, 382–391. [Google Scholar] [CrossRef]
- Gutha, Y.; Pathak, J.L.; Zhang, W.; Zhang, Y.; Jiao, X. Antibacterial and wound healing properties of chitosan/poly(vinyl alcohol)/zinc oxide beads (CS/PVA/ZnO). Int. J. Biol. Macromol. 2017, 103, 234–241. [Google Scholar] [CrossRef]
- Pan, Y.; Li, X.; Jia, X.; Zhao, Y.; Li, H.; Zhang, L. Storage temperature without fluctuation enhances shelf-life and improves postharvest quality of peach. J. Food Process. Preserv. 2019, 43, e13881. [Google Scholar] [CrossRef]
- Cai, L.; Wan, J.; Li, X.; Li, J. Effects of different thawing methods on physicochemical properties and structure of largemouth bass (Micropterus salmoides). J. Food Sci. 2020, 85, 582–591. [Google Scholar] [CrossRef]
- Sanuja, S.; Agalya, A.; Umapathy, M. Synthesis and characterization of zinc oxide–neem oil–chitosan bionanocomposite for food packaging application. Int. J. Biol. Macromol. 2015, 74, 76–84. [Google Scholar] [CrossRef]
- Mukurumbira, A.; Mellem, J.; Amonsou, E.O. Effects of amadumbe starch nanocrystals on the physicochemical properties of starch biocomposite films. Carbohydr. Polym. 2017, 165, 142–148. [Google Scholar] [CrossRef] [PubMed]
- Rahman, P.M.; Mujeeb, V.A.; Muraleedharan, K.; Thomas, S.K. Chitosan/nano ZnO composite films: Enhanced mechanical, antimicrobial and dielectric properties. Arab. J. Chem. 2018, 11, 120–127. [Google Scholar] [CrossRef] [Green Version]
- Wang, H.; Gong, X.; Guo, X.; Liu, C.; Fan, Y.-Y.; Zhang, J.; Niu, B.; Li, W. Characterization, release, and antioxidant activity of curcumin-loaded sodium alginate/ZnO hydrogel beads. Int. J. Biol. Macromol. 2018, 121, 1118–1125. [Google Scholar] [CrossRef] [PubMed]
- Yusof, N.A.A.; Zain, N.M.; Pauzi, N. Synthesis of ZnO nanoparticles with chitosan as stabilizing agent and their antibacterial properties against Gram-positive and Gram-negative bacteria. Int. J. Biol. Macromol. 2018, 124, 1132–1136. [Google Scholar] [CrossRef] [PubMed]
- Muraleedaran, K.; Mujeeb, V.A. Applications of chitosan powder with in situ synthesized nano ZnO particles as an antimicrobial agent. Int. J. Biol. Macromol. 2015, 77, 266–272. [Google Scholar]
- Malini, M.; Thirumavalavan, M.; Yang, W.-Y.; Lee, J.-F.; Annadurai, G. A versatile chitosan/ZnO nanocomposite with enhanced antimicrobial properties. Int. J. Biol. Macromol. 2015, 80, 121–129. [Google Scholar] [CrossRef]
- Zhang, X.; Zhang, Z.; Wu, W.; Yang, J.; Yang, Q. Preparation and characterization of chitosan/Nano-ZnO composite film with antimicrobial activity. Bioprocess Biosyst. Eng. 2021, 44, 1193–1199. [Google Scholar] [CrossRef] [PubMed]
- Shankar, S.; Teng, X.; Rhim, J.W. Effects of Concentration of ZnO Nanoparticles on Mechanical, Optical, Thermal, and Antimicrobial Properties of Gelatin/ZnO Nanocomposite Films. Korean J. Packag. Sci. Technol. 2014, 20, 41–49. [Google Scholar]
- Qiu, B.; Xu, X.-F.; Deng, R.-H.; Xia, G.-Q.; Shang, X.-F.; Zhou, P.-H. Construction of chitosan/ZnO nanocomposite film by in situ precipitation. Int. J. Biol. Macromol. 2018, 122, 82–87. [Google Scholar] [CrossRef]
- Mittal, H.; Ray, S.S.; Kaith, B.S.; Bhatia, J.K.; Sharma, J.; Alhassan, S.M. Recent progress in the structural modification of chitosan for applications in diversified biomedical fields. Eur. Polym. J. 2018, 109, 402–434. [Google Scholar] [CrossRef]
- Liu, Y.; Cai, Y.; Jiang, X.; Wu, J.; Le, X. Molecular interactions, characterization and antimicrobial activity of curcumin–chitosan blend films. Food Hydrocoll. 2016, 52, 564–572. [Google Scholar] [CrossRef]
- Zhu, Y.; Li, D.; Belwal, T.; Li, L.; Chen, H.; Xu, T.; Luo, Z. Effect of Nano-SiOx/Chitosan Complex Coating on the Physicochemical Characteristics and Preservation Performance of Green Tomato. Molecules 2019, 24, 4552. [Google Scholar] [CrossRef] [PubMed] [Green Version]
- Sammi, S.; Masud, T. Effect of different packaging systems on the quality of tomato (Lycopersicon esculentum var. Rio Grande) fruits during storage. Int. J. Food Sci. Technol. 2009, 44, 918–926. [Google Scholar] [CrossRef]
- Ali, A.; Muhammad, M.T.M.; Sijam, K.; Siddiqui, Y. Effect of chitosan coatings on the physicochemical characteristics of Eksotika II papaya (Carica papaya L) fruit during cold storage. Food Chem. 2011, 124, 620–626. [Google Scholar] [CrossRef]
- Paul, S.K.; Sarkar, S.; Sethi, L.N.; Ghosh, S.K. Development of chitosan based optimized edible coating for tomato (Solanum lycopersicum) and its characterization. J. Food Sci. Technol. 2018, 55, 2446–2456. [Google Scholar] [CrossRef] [PubMed]
- Das, D.K.; Dutta, H.; Mahanta, C.L. Development of a rice starch-based coating with antioxidant and microbe-barrier properties and study of its effect on tomatoes stored at room temperature. Food Sci. Technol. 2013, 50, 272–278. [Google Scholar] [CrossRef]
- Wu, S.; Lu, M.; Wang, S. Effect of oligosaccharides derived from Laminaria japonica-incorporated pullulan coatings on preservation of cherry tomatoes. Food Chem. 2016, 199, 296–300. [Google Scholar] [CrossRef] [PubMed]
- Dong, F.; Wang, X. Guar gum and ginseng extract coatings maintain the quality of sweet cherry. Food Sci. Technol. 2018, 89, 117–122. [Google Scholar] [CrossRef]
- Xin, Y.; Chen, F.; Lai, S.; Yang, H. Influence of chitosan-based coatings on the physicochemical properties and pectin nanostructure of Chinese cherry. Postharvest Biol. Technol. 2017, 133, 64–71. [Google Scholar] [CrossRef]
- Petriccione, M.; De Sanctis, F.; Pasquariello, M.S.; Mastrobuoni, F.; Rega, P.; Scortichini, M.; Mencarelli, F. The Effect of Chitosan Coating on the Quality and Nutraceutical Traits of Sweet Cherry During Postharvest Life. Food Bioprocess Technol. 2014, 8, 394–408. [Google Scholar] [CrossRef]
- Suo, B.; Li, H.; Wang, Y.; Li, Z.; Pan, Z.; Ai, Z. Effects of ZnO nanoparticle-coated packaging film on pork meat quality during cold storage. J. Sci. Food Agric. 2016, 97, 2023–2029. [Google Scholar] [CrossRef]
- Jin, T.; Sun, D.; Su, J.Y.; Zhang, H.; Sue, H.-J. Antimicrobial Efficacy of Zinc Oxide Quantum Dots against Listeria monocytogenes, Salmonella Enteritidis, and Escherichia coli O157:H7. J. Food Sci. 2009, 74, M46–M52. [Google Scholar] [CrossRef] [PubMed]
- Sun, J.; Jiang, H.; Wu, H.; Tong, C.; Pang, J.; Wu, C. Multifunctional bionanocomposite films based on konjac glucomannan/chitosan with nano-ZnO and mulberry anthocyanin extract for active food packaging. Food Hydrocoll. 2020, 107, 105942. [Google Scholar] [CrossRef]
- Li, L.-H.; Deng, J.-C.; Deng, H.-R.; Liu, Z.-L.; Xin, L. Synthesis and characterization of chitosan/ZnO nanoparticle composite membranes. Carbohydr. Res. 2010, 345, 994–998. [Google Scholar] [CrossRef] [PubMed]
- Zhang, Z.-Y.; Xiong, H.-M. Photoluminescent ZnO Nanoparticles and Their Biological Applications. Materials 2015, 8, 3101–3127. [Google Scholar] [CrossRef]

Publisher’s Note: MDPI stays neutral with regard to jurisdictional claims in published maps and institutional affiliations. |
© 2021 by the authors. Licensee MDPI, Basel, Switzerland. This article is an open access article distributed under the terms and conditions of the Creative Commons Attribution (CC BY) license (https://creativecommons.org/licenses/by/4.0/).
Share and Cite
Li, Y.; Zhou, Y.; Wang, Z.; Cai, R.; Yue, T.; Cui, L. Preparation and Characterization of Chitosan–Nano-ZnO Composite Films for Preservation of Cherry Tomatoes. Foods 2021, 10, 3135. https://doi.org/10.3390/foods10123135
Li Y, Zhou Y, Wang Z, Cai R, Yue T, Cui L. Preparation and Characterization of Chitosan–Nano-ZnO Composite Films for Preservation of Cherry Tomatoes. Foods. 2021; 10(12):3135. https://doi.org/10.3390/foods10123135
Chicago/Turabian StyleLi, Yu, Yu Zhou, Zhouli Wang, Rui Cai, Tianli Yue, and Lu Cui. 2021. "Preparation and Characterization of Chitosan–Nano-ZnO Composite Films for Preservation of Cherry Tomatoes" Foods 10, no. 12: 3135. https://doi.org/10.3390/foods10123135
APA StyleLi, Y., Zhou, Y., Wang, Z., Cai, R., Yue, T., & Cui, L. (2021). Preparation and Characterization of Chitosan–Nano-ZnO Composite Films for Preservation of Cherry Tomatoes. Foods, 10(12), 3135. https://doi.org/10.3390/foods10123135
